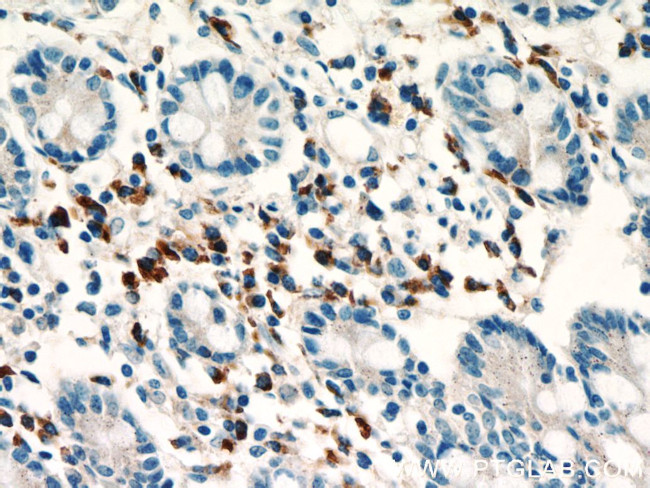
SDF2L1 Antibody in Immunohistochemistry (Paraffin) (IHC (P))
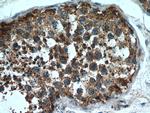
SDF2L1 Antibody in Immunohistochemistry (Paraffin) (IHC (P))
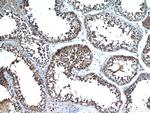
SDF2L1 Antibody in Immunohistochemistry (Paraffin) (IHC (P))

Search
Proteintech
SDF2L1 Polyclonal Antibody
{{$productOrderCtrl.translations['antibody.pdp.commerceCard.promotion.promotions']}}
{{$productOrderCtrl.translations['antibody.pdp.commerceCard.promotion.viewpromo']}}
{{$productOrderCtrl.translations['antibody.pdp.commerceCard.promotion.promocode']}}: {{promo.promoCode}} {{promo.promoTitle}} {{promo.promoDescription}}. {{$productOrderCtrl.translations['antibody.pdp.commerceCard.promotion.learnmore']}}
产品信息
20888-1-AP
种属反应
宿主/亚型
分类
类型
抗原
偶联物
形式
浓度
规格
纯化类型
保存液
内含物
保存条件
运输条件
产品详细信息
Immunogen sequence: AKTGAELVT CGSVLKLLNT HHRVRLHSHD IKYGSGSGQQ SVTGVEASDD ANSYWRIRGG SEGGCPRGSP VRCGQAVRLT HVLTGKNLHT HHFPSPLSNN QEVSAFGEDG EGDDLDLWTV RCSGQHWERE AAVRFQHVGT SVFLSVTGEQ YGSPIRGQHE VHGMPSANTH NTWKAMEGIF IKPSVEPSAG HDEL (19-211 aa encoded by BC006248)
靶标信息
The specific function of the protein remains unknown.
仅用于科研。不用于诊断过程。未经明确授权不得转售。
生物信息学
蛋白别名: dihydropyrimidinase-like 2; PWP1-interacting protein 8; SDF2-like 1; SDF2-like protein 1; SDF2L1; Stromal cell-derived factor 2-like protein 1
基因别名: SDF2L1; UNQ1941/PRO4424
UniProt ID: (Human) Q9HCN8, (Mouse) Q9ESP1
Entrez Gene ID: (Human) 23753, (Rat) 680945, (Mouse) 64136